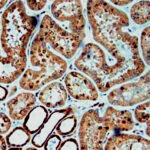

|
|---|
 Anti-Glial Fibrillary Acidic Protein (GFAP) Anti-Glial Fibrillary Acidic Protein (GFAP)Buy here |
 Anti-Glial Fibrillary Acidic Protein (GFAP) Anti-Glial Fibrillary Acidic Protein (GFAP)Buy here |
 Anti-Glial Fibrillary Acidic Protein (GFAP) Anti-Glial Fibrillary Acidic Protein (GFAP)Buy here |
 Anti-Glucagon Anti-GlucagonBuy here |
 Anti-GLUT 1 Anti-GLUT 1Buy here |
 Anti-GLUT-1 Anti-GLUT-1Buy here |
 Anti-Glutathione S-Transferase Pi (GST Pi) Anti-Glutathione S-Transferase Pi (GST Pi)Buy here |
 Anti-Glycophorin A + B Anti-Glycophorin A + BBuy here |
 Anti-Glycophorin A, Clone JC159 Anti-Glycophorin A, Clone JC159Buy here |
 Anti-Glypican-3 (GPC3) Anti-Glypican-3 (GPC3)Buy here |